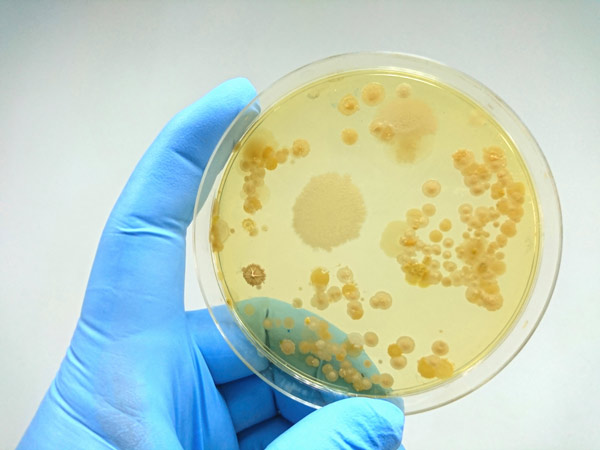
image of bacterial colonies on a culture medium

Apr. 9, 2026 Research Highlight Biology
How microbes grow when multiple resources are limited
An 80-year-old expression that predicts how microbes grow has been generalized to account for multiple nutrients
Figure 1: Bacterial colonies on a culture medium. Two researchers have derived a theoretical framework that predicts microbial growth when it is limited by more than one resource.© TON_AQUATIC, CHOKSAWATDIKORN/SCIENCE PHOTO LIBRARYY
A general law that describes how microbes proliferate when they have limited resources has been theoretically derived by a RIKEN biophysicist and a collaborator1. This expression, which generalizes one developed about 80 years ago, will be useful for optimizing nutrient feeds and growth conditions in bioreactors and fermenters.
Scientists have long been interested in modeling how microbes multiply under different conditions.
An expression known as Monod’s law, developed in the 1940s, does a good job of predicting how microbes increase with the concentration of one growth-limiting nutrient.
It says that microbial growth will initially increase rapidly with increasing nutrient concentration, but that this proliferation will taper off at higher concentrations. It is thus essentially an expression of the law of diminishing returns.
Monod’s law appears to indicate that a single biochemical reaction is responsible for limiting microbial growth. But microbial growth is highly complex, involving a web of thousands of biochemical processes. This raises the question of just how general Monod’s law is.
“Monod’s law has long been accepted as an empirical rule, but its underpinnings have remained unclear,” explains Jumpei Yamagishi of the RIKEN Center for Biosystems Dynamics Research. “The simplistic picture of cell growth being limited by a single biochemical process cannot explain the deviations from Monod’s law often seen in experiments.”
Now, Yamagishi and Tetsuhiro Hatakeyama of the Earth-Life Science Institute (ELSI) of Institute of Science Tokyo, have developed a more general framework for describing microbial growth that builds on Monod’s law.
“While Monod’s law considers only a single limiting nutrient, our global constraint principle yields qualitative yet general predictions about growth when multiple nutrients limit growth simultaneously,” notes Yamagishi.
Yamagishi and Hatakeyama extended Monod’s law by combining it with another phenomenological growth law known as Liebig’s law of the minimum, which states that the availability of multiple resources collectively limits the growth of organisms. This combination allowed the pair to derive a formulation that factors in multiple nutrients.
The researchers confirmed the accuracy of their model by performing numerical simulations of bacterial growth. They also confirmed that their model agreed qualitatively with published experimental data.
The model is useful for practical applications. “The framework can guide how to adjust nutrient feeds and environmental conditions in bioreactors and fermenters to achieve the desired growth,” says Yamagishi. “And it offers theoretical insights for identifying limiting resources in complex media.”
Yamagishi anticipates that this advance will catalyze further work in this area. “We expect this to stimulate further theoretical work that systematically connects phenomenological growth laws with optimization-based models,” he says. “I’m optimistic that substantial theoretical progress is possible within the next five to ten years.”

The model for describing the growth of microbes can be pictured as water (indicating a resource) being poured into a barrel made of staves having different heights. © 2026 RIKEN
Rate this article
Reference
- 1. Yamagishi, J. F. & Hatakeyama, T. S. Global constraint principle for microbial growth laws. Proceedings of the National Academy of Sciences of the USA 122, e2515031122 (2025). doi: 10.1073/pnas.2515031122
